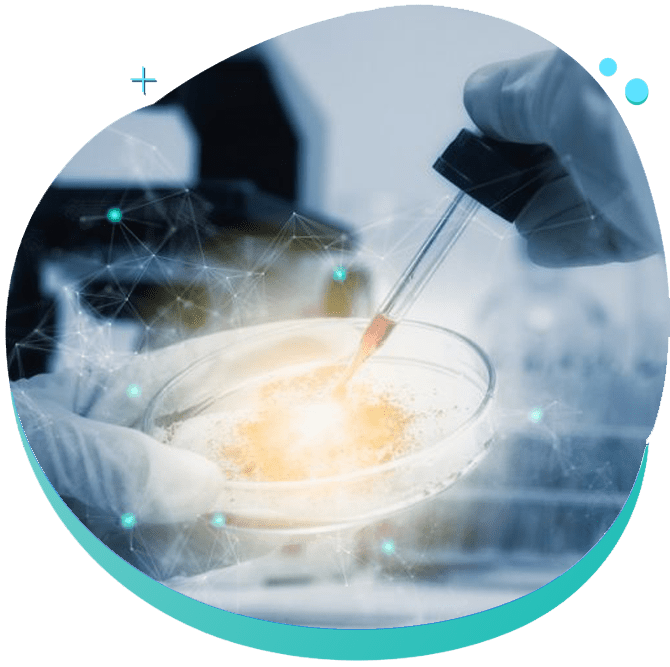

Cord Blood Stem Cells Treatment
Cord Blood Is Currently Utilized In The Treatment Of Around 80 Diseases*
Including different types of lymphoma and anaemia. By saving the cord blood of your baby, you are therefore getting a potentially lifesaving option available for your child, and your family.
Time To Share The Love And Guidance
Your child is able to use his stem cells when the need arises, this is known as Autologous Transplant. However, it can also be shared by the siblings in the family after suitable matching; such cases are known as Allogeneic Transplant.
Hematopoietic cell transplantation (HCT) of umbilical cord origin can benefit for malignant and nonmalignant diseases like Fanconi’s anemia, aplastic anemia, leukemias, bone marrow failure syndromes, inborn error of metabolism, congenital disorders and hemoglobinopathies
Note: The Sources of disease information are publications in the medical literature that were found by keyword searches of PubMed and Google Scholar. All these are cited in our “Literature & References” page.
DISEASES TREATABLE WITH CORD BLOOD BANKING
Diseases that may be treated with cord blood transplant as standard treatment include:
| Diseases | Cord Blood Transplant “Standard Treatment” | |
|---|---|---|
| Blood Disorders | Leukemia is a cancer of the immune system, where the cells are called leukocytes or white cells | Acute Lymphoblastic Leukemia (ALL) |
| Acute Myelogenous Leukemia (AML) | ||
| Acute Biphenotypic Leukemia | ||
| Acute Undifferentiated Leukemia | ||
| Chronic Lymphocytic Leukemia (CLL) | ||
| Chronic Myelogenous Leukemia (CML) | ||
| Juvenile Chronic Myelogenous Leukemia (JCML) | ||
| Juvenile Myelomonocytic Leukemia (JMML) | ||
| Myelodysplastic Syndromes are also called pre-leukemia | ||
| Myelodysplastic Syndromes are also called pre-leukemia | Refractory Anemia | |
| Refractory Anemia with Ringed Sideroblasts (Sideroblastic anemia) | ||
| Refractory Anemia with Excess Blasts | ||
| Refractory Anemia with Excess Blasts in Transformation | ||
| Chronic Myelomonocytic Leukemia (CMML) | ||
| Lymphomas is a solid tumors of leukocytes that circulate in the blood and lymph vessels | Hodgkin’s Lymphoma | |
| Non-Hodgkin’s Lymphoma including Burkitt’s Lymphoma | ||
| Blood cell proliferation disorders | Anemias are deficiencies or malformations of red cells | Fanconi Anemia
(The first cord blood transplant in 1988 was for FA, an inherited disorder |
| Congenital Dyserythropoietic Anemia | ||
| Paroxysmal Nocturnal Hemoglobinuria (PNH) | ||
| Inherited Red Cell Abnormalities | ||
| Sickle Cell Disease | ||
| Beta Thalassemia Major (aka Cooley’s Anemia) | ||
| Diamond-Blackfan Anemia | ||
| Pure Red Cell Aplasia | ||
| Inherited Platelet Abnormalities | ||
| Amegakaryocytosis / Congenital Thrombocytopenia | ||
| Glanzmann Thrombasthenia | ||
| Inherited Immune System Disorders | Severe Combined Immunodeficiency | SCID with Adenosine Deaminase Deficiency (ADA-SCID) |
| SCID which is X-linked | ||
| SCID with absence of T & B Cells | ||
| SCID with absence of T Cells, Normal B Cells | ||
| Omenn Syndrome | ||
| Neutropenias | ||
| Infantile Genetic Agranulocytosis (Kostmann Syndrome) | ||
| Myelokathexis | ||
| Others | Ataxia-Telangiectasia | |
| Bare Lymphocyte Syndrome | ||
| DiGeorge Syndrome | ||
| Hemophagocytic Lymphohistiocytosis | ||
| Leukocyte Adhesion Deficiency | ||
| Leukocyte Adhesion Deficiency | ||
| Lymphoproliferative Disorder, X-linked (Susceptibility to Epstein-Barr virus) | ||
| Wiskott-Aldrich Syndrome | ||
| Myeloproliferative Disorders | ||
| Acute Myelofibrosis | ||
| Agnogenic Myeloid Metaplasia (Myelofibrosis) | ||
| Polycythemia Vera | ||
| Essential Thrombocythemia | ||
| Phagocyte Disorders | These are immune system cells that engulf and kill foreign organisms | Chediak-Higashi Syndrome |
| Chronic Granulomatous Disease | ||
| Neutrophil Actin Deficiency | ||
| Reticular Dysgenesis | ||
| Bone Marrow Cancers | Multiple Myeloma | |
| Plasma Cell Leukemia | ||
| Waldenstrom’s Macroglobulinemi | ||
| Inherited Disorders of the Immune System & Other Organs | Cartilage-Hair Hypoplasia | |
| Erythropoietic Porphyria | ||
| Hermansky-Pudlak Syndrome | ||
| Pearson’s Syndrome | ||
| Shwachman-Diamond Syndrome | ||
| Systemic Mastocytosis | ||
| Inherited Metabolic Disorders | Mucopolysaccharidosis (MPS) Storage Diseases | Hurler Syndrome (MPS-IH) |
| Scheie Syndrome (MPS-IS) | ||
| Hunter Syndrome (MPS-II) | ||
| Sanfilippo Syndrome (MPS-III) | ||
| Morquio Syndrome (MPS-IV) | ||
| Maroteaux-Lamy Syndrome (MPS-VI) | ||
| Sly Syndrome (MPS-VII) (beta-glucuronidase deficiency) | ||
| Mucolipidosis II (I-cell Disease) | ||
| Leukodystrophy Disorders | ||
| Adrenoleukodystrophy (ALD) | ||
| Krabbe Disease (Globoid Cell Leukodystrophy) | ||
| Metachromatic Leukodystrophy | ||
| Pelizaeus-Merzbacher Disease | ||
| Lysosomal Storage Diseases | Niemann-Pick Disease | |
| Sandhoff Disease | ||
| Wolman Disease | ||
| Other | Lesch-Nyhan Syndrome | |
| Osteoporosis/Osteopetrosis | ||


